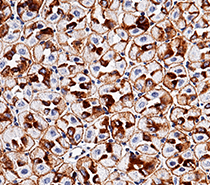
ADC target antigens in solid tumors

Antibody–drug conjugates (ADCs) are exciting new anticancer therapeutics. ADCs include target-specific monoclonal antibodies (mAbs), cytotoxic drugs, and chemically synthesized linkers that covalently bind them.
ADCs are a rapidly growing drug therapy for solid tumors due to the cytotoxic effects of chemotherapeutic drugs combined with antibodies targeting tumor-associated antigens (TAAs).
The ADCs mAb attaches to specific antigens on the surface of tumor cells, and ADCs are internalized into tumor cells during the formation of the antibody–antigen complex. ADCs are typically moved from the endosome to the lysosome, where the linker is divided and small molecule cytotoxic drugs are released, resulting in tumor cell death.
In addition to the long-standing ADC target antigens, such as FGFR, EGFR, c-MET, and HER2, new targets like EpCAM, TROP-2, CD25, and others (Table 1) are being researched and show promise in the treatment of solid tumors.
Sino Biological is at the forefront of advancing ADC therapy for treating solid tumors by providing high-quality ADC target antigens.
Table 1. ADC target antigens at the preclinical and clinical stages. Source: Sino Biological Inc.
| Various categories of ADCs in clinical and preclinical stages |
ADC target antigens |
| Well-established ADC TAAs |
HER2, EGFR, EGFRvIII, c-MET, FGFR2, FGFR3 |
| ADC TAAs overexpressed on cancer cells |
EpCAM, BCMA, TROP-2, AXL, HER3, CD166, CEACAM5, GPNMB, Mesothelin, CD70 |
| Target antigens in TME |
CD25/IL2R, B7-H3, ANTXR1 |
| Target antigens in CSCs |
PTK7, ROR1, 5T4 |

Figure 1. General mechanism of action of ADCs. Image Credit: Sino Biological Inc.
Sino Biological offers superior products that have been substantiated for activity and are highly regarded by users, as evidenced by citations in top-tier journals.
- High-purity
- High-activity
- HPLC-verified
- Cited by researchers
Human EGFR protein Cat#: 10001-H27H-B

Immobilized Human EGF (Cat#: 10605-H01H) can bind Human EGFR. Image Credit: Sino Biological Inc.
Human c-MET protein Cat#: 10692-H08H

Immobilized Cynomolgus HGF (Cat#: 90286-CNAH) can bind Human c-MET. Image Credit: Sino Biological Inc.
Human CD25/IL2R alpha protein Cat#: 10165-H08H

Ability to inhibit IL2-induced proliferation of M07e cells. Image Credit: Sino Biological Inc.
Human BCMA protein Cat#: 10620-H08H

Immobilized Human BAFF (Cat#: 10056-H01H) can bind Human BCMA. Image Credit: Sino Biological Inc.
Human CD70 protein Cat#: 10780-H01H

Immobilized Human CD27 (Cat#: 10039-H08B1) can bind Human CD70. Image Credit: Sino Biological Inc.
Human CD166/ALCAM protein Cat#: 10045-H08H

Immobilized human CD166 can bind mouse CD6. Image Credit: Sino Biological Inc.
More recombinant proteins (Partial)
Table 2. Source: Sino Biological Inc.
| Cat# |
Molecule |
Species |
Expression Host |
Purity |
Activity |
| 10001-H08H |
EGFR |
Human |
HEK293 Cells |
> 90 % |
Active |
| 51091-M08H |
Mouse |
HEK293 Cells |
> 85 % |
Active |
| 80100-R08H |
Rat |
HEK293 Cells |
> 98 % |
Active |
| 90317-K02H |
Rhesus |
HEK293 Cells |
> 95 % |
|
| 90285-C08H |
Cynomolgus |
HEK293 Cells |
> 90 % |
Active |
| 10692-H27H-B |
c-MET |
Human |
HEK293 Cells |
> 95 % |
Active |
| 50622-M08H |
Mouse |
HEK293 Cells |
> 90% |
Active |
| 80004-R02H |
Rat |
HEK293 Cells |
> 95 % |
Active |
| 90304-C08H-B |
Cynomolgus, Rhesus |
HEK293 Cells |
> 90 % |
|
| 10694-H08H |
EpCAM |
Human |
HEK293 Cells |
≥ 90 % |
Active |
| 50591-M08H |
Mouse |
HEK293 Cells |
> 95 % |
|
| 80306-R08H |
Rat |
HEK293 Cells |
> 97 % |
|
| 10428-H03H |
TROP2 |
Human |
HEK293 Cells |
> 98 % |
Active |
| 50922-M02H |
Mouse |
HEK293 Cells |
> 95 % |
Active |
| 86246-R08H |
Rat |
HEK293 Cells |
> 90 % |
|
| 10165-H02H |
CD25/IL2Rα |
Human |
HEK293 Cells |
> 90 % |
Active |
| 50292-M02H |
Mouse |
HEK293 Cells |
> 95 % |
Active |
| 80074-R08B |
Rat |
Baculovirus-Insect Cells |
> 95 % |
|
| 90265-C02H |
Cynomolgus |
HEK293 Cells |
> 90 % |
Active |
| 10620-H40H-B |
BCMA |
Human |
HEK293 Cells |
> 95 % |
Active |
| 50076-M42H-B |
Mouse |
HEK293 Cells |
> 90 % |
Active |
| 90103-C35H-B |
Rhesus |
HEK293 Cells |
> 95 % |
Active |
| 10824-H03H |
FGFR2 |
Human |
HEK293 Cells |
> 90 % |
Active |
| 51128-M02H |
Mouse |
HEK293 Cells |
> 95 % |
Active |
| 16486-H02H |
FGFR3 |
Human |
HEK293 Cells |
> 95 % |
Active |
| 50071-M08H |
Mouse |
HEK293 Cells |
> 98 % |
Active |
| 90313-C02H |
Cynomolgus |
HEK293 Cells |
> 90 % |
Active |
| 50005-M03H |
CD166/ALCAM |
Mouse |
HEK293 Cells |
> 95 % |
Active |
| 80221-R02H |
Rat |
HEK293 Cells |
> 95 % |
Active |
| 90227-C08H |
Cynomolgus |
HEK293 Cells |
> 95 % |
Active |
| 51129-M04H |
CD70 |
Mouse |
HEK293 Cells |
> 95 % |
Active |
| 80161-R01H |
Rat |
HEK293 Cells |
> 95 % |
Active |
| 10279-H08H |
AXL |
Human |
HEK293 Cells |
> 90 % |
|
| 50126-M08H |
Mouse |
HEK293 Cells |
> 98 % |
|
| 83136-R08H |
Rat |
HEK293 Cells |
> 95 % |
|
| 10201-H02H |
HER3 |
Human |
HEK293 Cells |
> 90 % |
Active |
| 51003-M08H |
Mouse |
HEK293 Cells |
> 93 % |
Active |
| 80111-R08H |
Rat |
HEK293 Cells |
> 95 % |
Active |
| 11077-H27H-B |
CEACAM5 |
Human |
HEK293 Cells |
> 95 % |
|
| 54867-M02H1 |
Mouse |
HEK293 Cells |
> 90 % |
|
| 11305-H02H |
GPNMB |
Human |
HEK293 Cells |
> 95 % |
|
| 13128-H08H |
Mesothelin |
Human |
HEK293 Cells |
> 90 % |
|
| 11188-H02H |
B7-H3 |
Human |
HEK293 Cells |
> 95 % |
|
| 50973-M02H |
Mouse |
HEK293 Cells |
> 95 % |
|
| 13367-H02H |
ANTXR1 |
Human |
HEK293 Cells |
> 90 % |
|
| 19399-H08H |
CCK4/PTK7 |
Human |
HEK293 Cells |
> 95 % |
|
| 13968-H20B |
ROR1 |
Human |
Baculovirus-Insect Cells |
> 85 % |
Active |
| 13968-H02H1 |
Human |
HEK293 Cells |
> 90 % |
|
| 19845-H08H |
5T4/TPBG |
Human |
HEK293 Cells |
> 95 % |
|
Other related proteins
- TIM-1
- CD56
- EpCAM
- Siglec-2
- Ly75
- CD228
- Fra
- Nectin-4
- MUC1
- CD71
- ENPP3
- Liv1
Antibodies for ADC target antigens
Sino Biological has created a panel of antibodies for ADC target antigens that can be used in ELISA, IHC, IP, FCM, and WB, among other applications.
Anti-EpCAM antibody rabbit MAb Cat#: 50591-R002
Immunochemical staining of mouse EpCAM in mouse stomach. Image Credit: Sino Biological Inc.
Anti-EGFR antibody rabbit MAb Cat#: 10001-R021

Immunofluorescence staining of Human EGFR in A431 cells. Image Credit: Sino Biological Inc.
Anti-c-MET antibody rabbit MAb Cat#: 10692-R271-A

Profile of anti-human C-Met reactivity on HepG2 cells analyzed by flow cytometry. Image Credit: Sino Biological Inc.
More antibodies for ADC target antigens (Partial)
Table 3. Source: Sino Biological Inc.
| Cat# |
Antigen |
Species |
Clonality |
Ig Type |
Application |
| 10001-R021 |
EGFR |
Human |
Rabbit MAb |
Rabbit IgG |
ELISA, ICC/IF |
| 10001-MM01 |
|
Human |
Mouse MAb |
Mouse IgG2b |
ELISA |
| 10692-R243-F |
c-MET |
Human |
Rabbit MAb |
Rabbit IgG |
FCM |
| 10692-MM02 |
|
Human |
Mouse MAb |
Mouse IgG1 |
ELISA |
| 10694-R028 |
EpCAM |
Human |
Rabbit MAb |
Rabbit IgG |
WB, ELISA, IHC-P, FCM, ICC/IF, IP |
| 10694-MM05 |
|
Human |
Mouse MAb |
Mouse IgG1 |
WB |
| 10428-R001 |
TROP2 |
Human |
Rabbit MAb |
Rabbit IgG |
ELISA, ICC/IF, FCM |
| 10428-MM01 |
|
Human |
Mouse MAb |
Mouse IgG1 |
ELISA, IHC-P, FCM |
| 50292-R049-C |
CD25/IL2Rα |
Mouse |
Rabbit MAb |
Rabbit IgG |
FCM |
| 10165-MM17-F |
|
Human |
Mouse MAb |
Mouse IgG1 |
FCM |
| 10620-R049 |
BCMA |
Human |
Rabbit MAb |
Rabbit IgG |
ELISA |
| 10824-R016 |
FGFR2 |
Human |
Rabbit MAb |
Rabbit IgG |
ELISA |
| 50071-R046 |
FGFR3 |
Mouse |
Rabbit MAb |
Rabbit IgG |
ELISA |
| 100550-MM07 |
|
Human |
Mouse MAb |
Mouse IgG1 |
IHC-P |
| 50005-R311 |
CD166/ALCAM |
Mouse |
Rabbit MAb |
Rabbit IgG |
ELISA, FCM |
| 10045-MM05 |
|
Human |
Mouse MAb |
Mouse IgG1 |
ELISA |
| 10279-R101-F |
AXL |
Human |
Rabbit MAb |
Rabbit IgG |
FCM |
| 10279-MM17 |
|
Human |
Mouse MAb |
Mouse IgG1 |
ELISA |
| 10201-R016 |
HER3 |
Human |
Rabbit MAb |
Rabbit IgG |
ELISA |
| 10201-MM01 |
|
Human |
Mouse MAb |
Mouse IgG1 |
ELISA |
| 11077-R327 |
CEACAM5 |
Human |
Rabbit MAb |
Rabbit IgG |
IHC-P |
| 11077-MM08 |
|
Human |
Mouse MAb |
Mouse IgG2a |
ELISA, IHC-P |
| 11305-R105 |
GPNMB |
Human |
Rabbit MAb |
Rabbit IgG |
ELISA |
| 13128-MM12 |
Mesothelin |
Human |
Mouse MAb |
Mouse IgG1 |
ELISA, IHC-P |
| 11188-MM06 |
B7-H3 |
Human |
Mouse MAb |
Mouse IgG2b |
ELISA, ICC/IF, FCM |
| 50973-R317 |
|
Mouse |
Rabbit MAb |
Rabbit IgG |
ELISA |
| 204330-T08 |
CCK4/PTK7 |
Human |
Rabbit PAb |
Rabbit IgG |
IHC-P |
| 13968-T16 |
ROR1 |
Human |
Rabbit PAb |
Rabbit IgG |
ELISA |
| 101430-T08 |
5T4/TPBG |
Human |
Rabbit PAb |
Rabbit IgG |
IHC-P |
References
- Tang H, Liu Y, Yu Z, et al. (2019) The analysis of key factors related to ADCs structural design[J]. Frontiers in Pharmacology, 10, p. 373.
- Cai X, Yu J, Fang T, et al. (2022) Antibody-Drug Conjugates Targeting the Human Epidermal Growth Factor Receptor (HER) Family in Cancers[J]. Frontiers in Molecular Biosciences, 184.